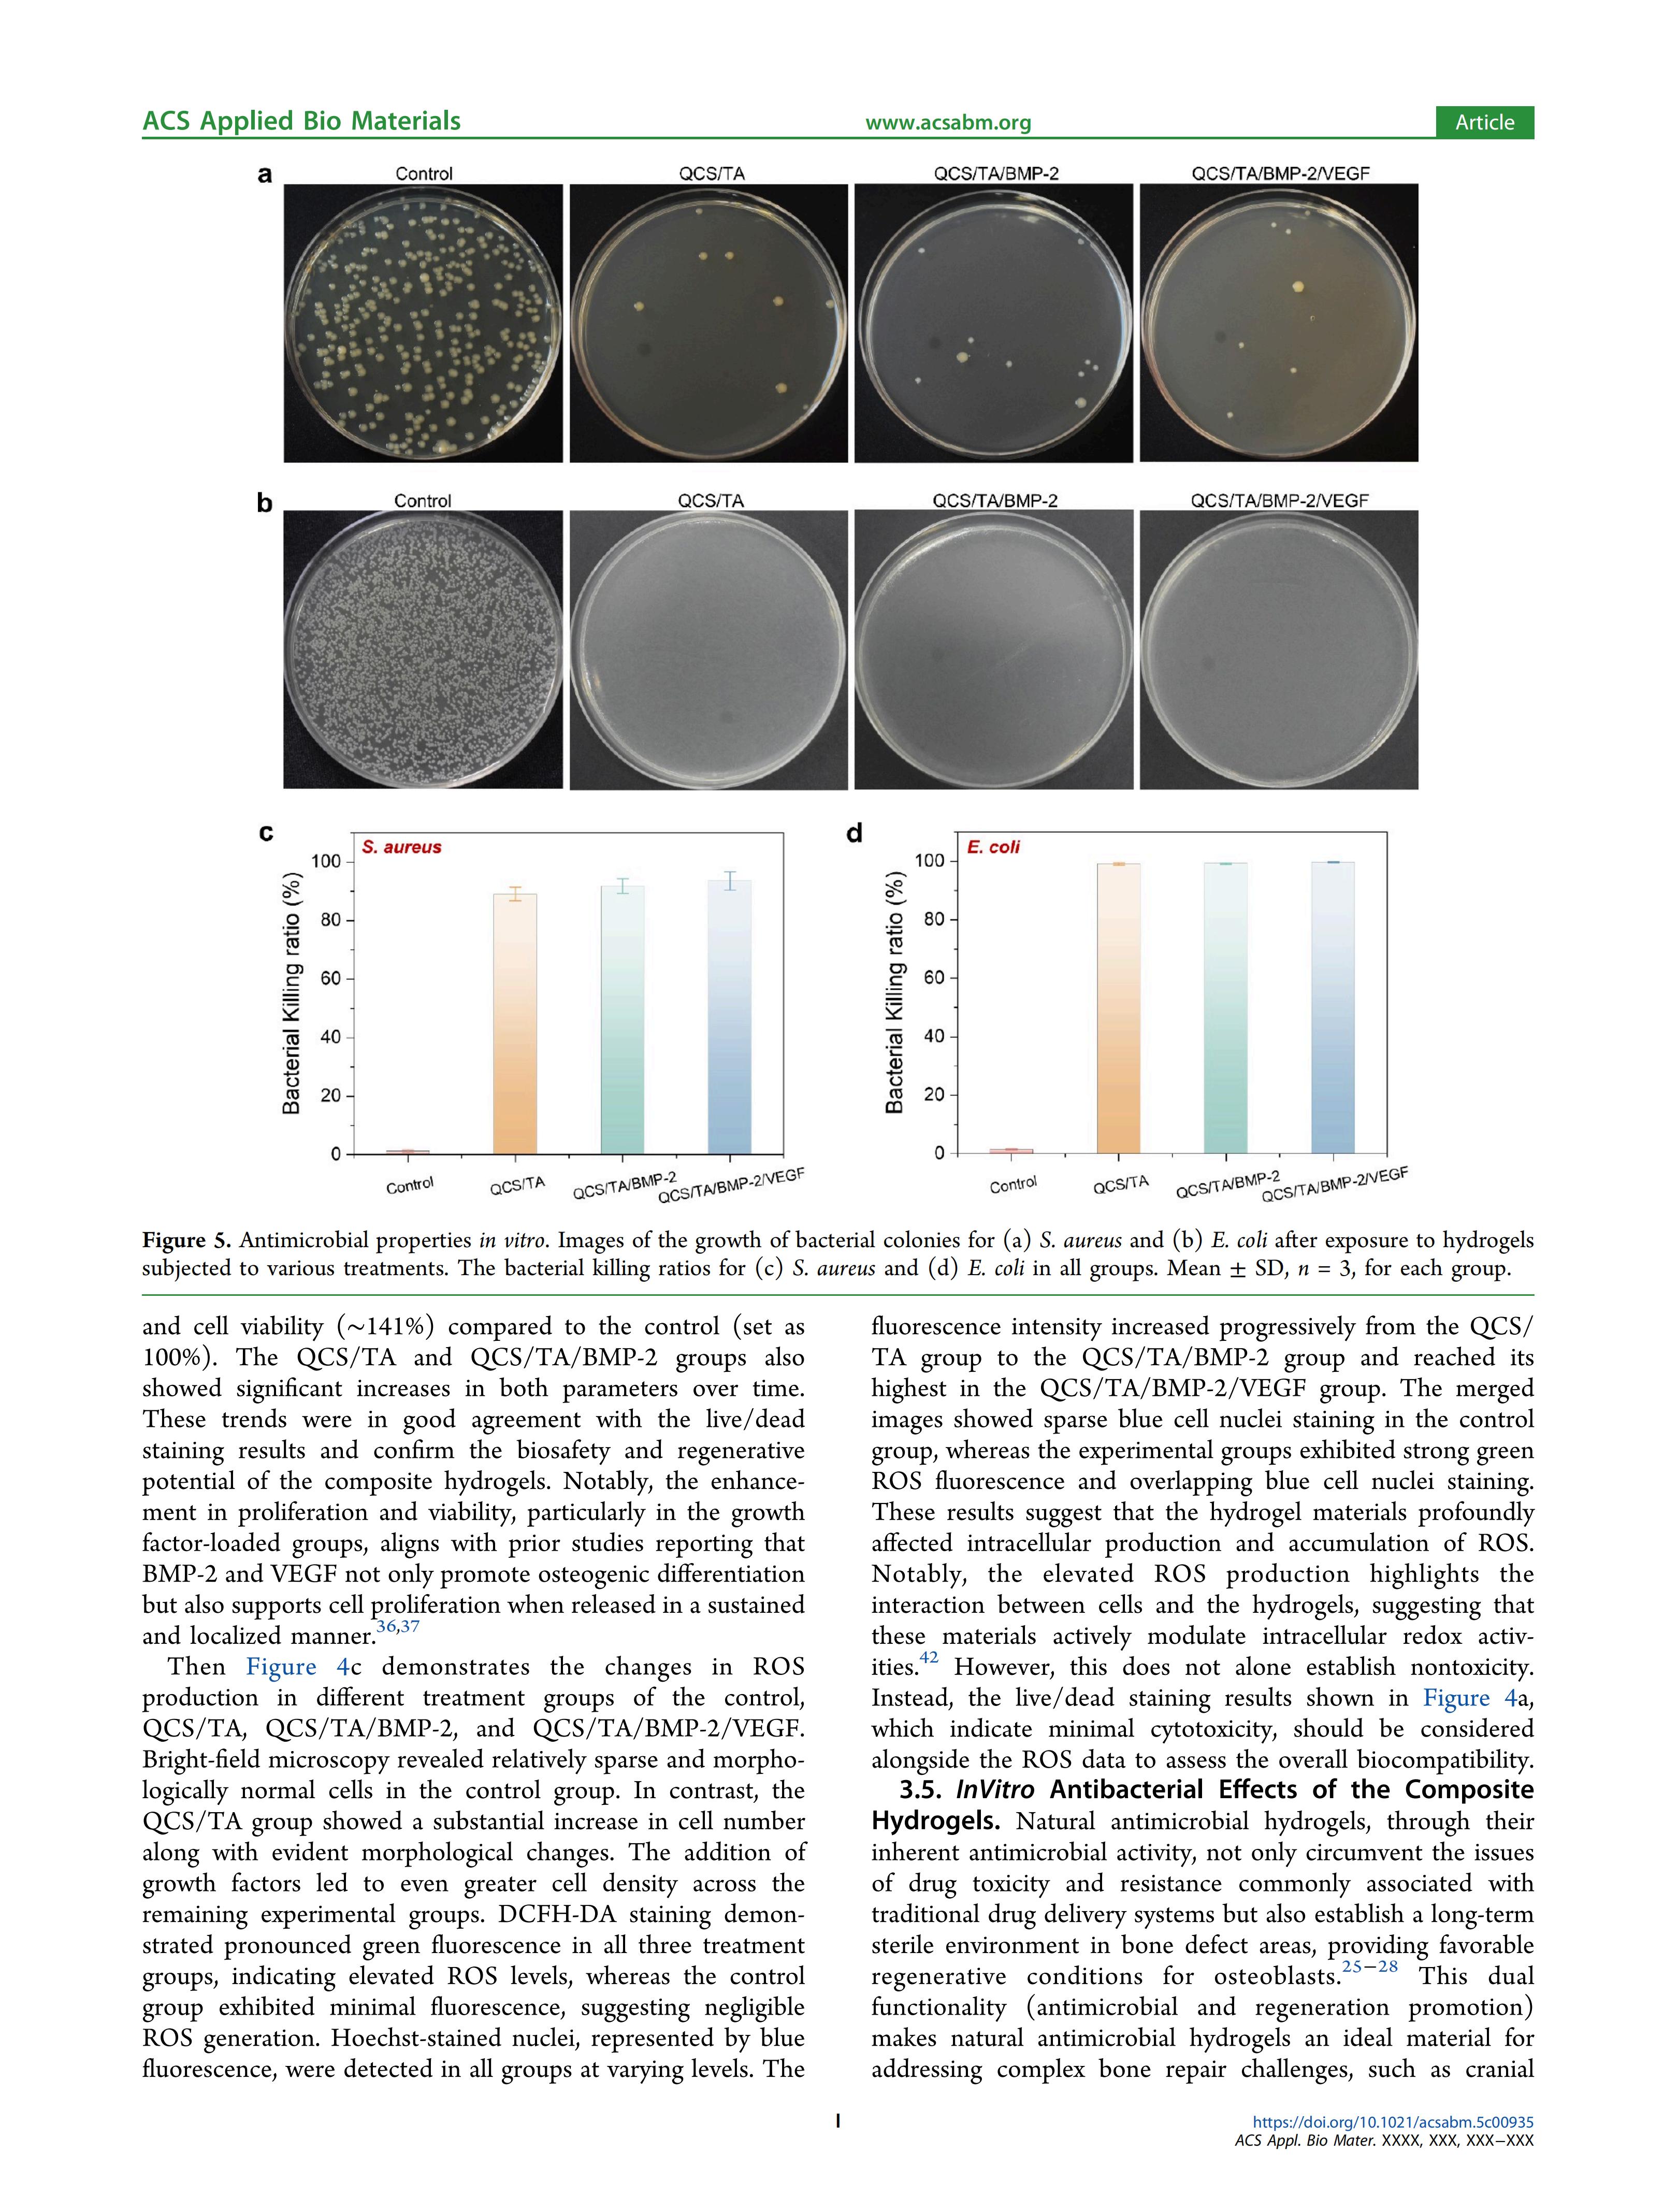
img

近日,我院医疗院长兼关节外科、运动医学科主任付昆教授与中国科学院深圳先进技术研究院 沈彤宇、教育部创伤与急诊重点实验室 海南医学院第一附属医院关节外科 刘泽宇、北京大学电子与计算机工程学院 刘艳欣合作,在国际知名学术期刊美国化学会《ACS Applied Bio Materials》上在线发表了题为“Injectable Antimicrobial Quaternary Chitosan Salt/Tannic Acid as aDelivery Platform for Enhanced Cranial Bone Regeneration via theSynergy of BMP‑2 and VEGF”(注射用抗菌季铵盐/单宁酸作为BMP-2和VEGF协同作用增强颅骨再生的递送平台)的学术论文。
海南中德骨科医院是该论文通讯单位之一,付昆教授为通讯作者。付昆教授作为教育部创伤与急诊重点实验室 原海南医学院第一附属医院关节外科主任 指导了该论文第一作者 刘泽宇。
处理大型不规则骨缺损仍是临床治疗中的重大挑战。该研究创新性地提出了一种可注射抗菌递送平台。该治疗系统通过结合季铵盐壳聚糖(QCS)与单宁酸(TA),并协同添加骨形态发生蛋白-2(BMP-2)和血管生成素(VEGF),显著提升再生效果。QCS与TA形成的氢键网络增强材料机械强度,而BMP-2和VEGF的靶向递送则促进成骨与血管生成。QCS/TA的长效抗菌特性进一步构建了理想的再生微环境。机制分析显示,QCS/TA/BMP-2/VEGF联合组中成骨基因表达显著上调,与体内实验结果高度吻合——8周内缺损闭合率接近80%。这种整合BMP-2和VEGF的可注射QCS/TA水凝胶平台为骨缺损修复提供了新思路,彰显其在攻克临床难题中的突破性价值。

该研究得到了海南省级卫生科技联合项目(WSJK2024MS228)、海南省级研究生科研创新项目(Qhys023-485)以及中国博士后科学基金特别资助项目(GZC20241848)的大力支持。
据了解,《ACS Applied Bio Materials》是一个跨学科的综合性期刊,主要出版生物相关材料领域的原创性研究工作,在生物材料、生物自组装材料与仿生材料、生物材料成像、生物能源、生物催化、生物电子学等领域均处于国际领先地位。
论文全文——

推荐新闻
-
以辩促研 严把质量关|海南医科大学硕士研究生毕业预答辩会在我院举行
-
琼澳连心愈骨伤 妙手仁心铸口碑——澳门62岁患者时隔三月专程返琼复查赠旗 点赞手足显微外科精湛医术
-
多学科“心”守护 共闯生命禁区——我院成功为95岁严重心衰老人完成髋关节置换
-
走进医疗世界,探索职业未来——海南中学2026年寒假职场体验活动在我院圆满落幕
-
寒假微创取钉“忙” 海南中德骨科医院“隐形”手术守护青少年健康成长
-
中国非公立医疗机构协会会长钱阳明一行来院调研指导 共探自贸港背景下社会办医差异化发展路径
-
海南中德骨科医院成功举办2025年度优秀员工表彰大会
-
医疗+保险 | 我院携手海保人寿海南分公司开启惠民服务新篇章
-
我院张宗恒院长在首届脊柱外科创新技术论坛分享创新成果并荣获佳绩
-
英国兰卡斯特大学心理学荣誉研究员Stefan Reinhold VOGT博士到访我院参观交流